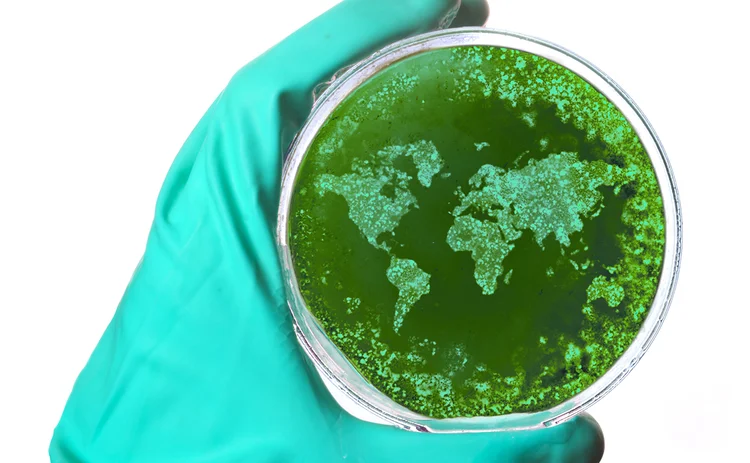

Axa pulls out of Biba conference over coronavirus fears
Exclusive: Axa UK&I, Axa XL and Axa Partners will not be attending the annual British Insurance Brokers’ Association’s conference in May due to concerns over coronavirus.
The coronavirus Covid-19 outbreak has been granted pandemic status by the World Health Organisation, while the UK has moved from a ‘contain’ to a ‘delay’ phase.
A number of insurers are known to have
Only users who have a paid subscription or are part of a corporate subscription are able to print or copy content.
To access these options, along with all other subscription benefits, please contact info@postonline.co.uk or view our subscription options here: https://subscriptions.postonline.co.uk/subscribe
You are currently unable to print this content. Please contact info@postonline.co.uk to find out more.
You are currently unable to copy this content. Please contact info@postonline.co.uk to find out more.
Copyright Infopro Digital Limited. All rights reserved.
As outlined in our terms and conditions, https://www.infopro-digital.com/terms-and-conditions/subscriptions/ (point 2.4), printing is limited to a single copy.
If you would like to purchase additional rights please email info@postonline.co.uk
Copyright Infopro Digital Limited. All rights reserved.
You may share this content using our article tools. As outlined in our terms and conditions, https://www.infopro-digital.com/terms-and-conditions/subscriptions/ (clause 2.4), an Authorised User may only make one copy of the materials for their own personal use. You must also comply with the restrictions in clause 2.5.
If you would like to purchase additional rights please email info@postonline.co.uk








